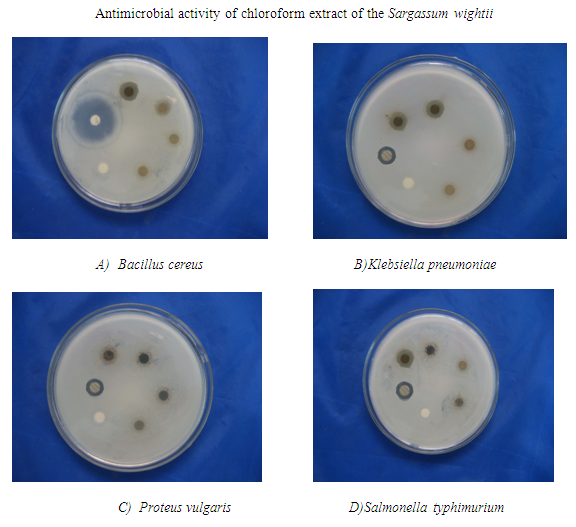
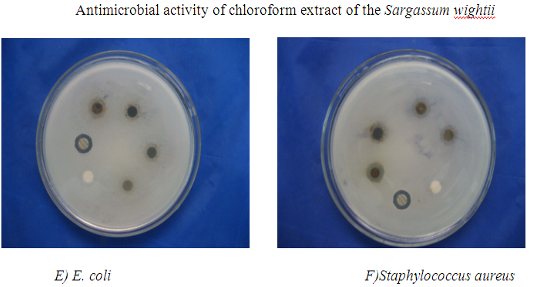
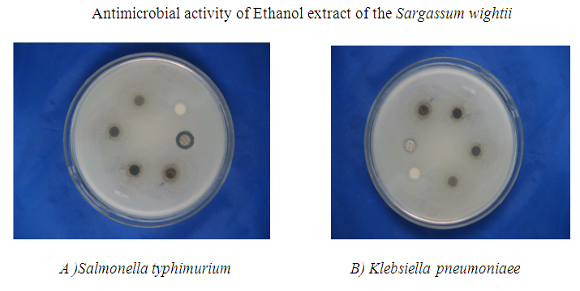
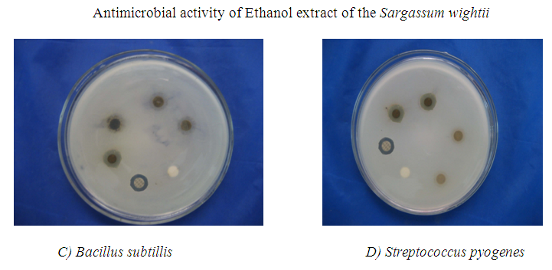

1Department of Biotechnology, School of Chemical & Biotechnology, SASTRA University, Thirumalaisamudram, Thanjavur 613401, Tamil Nadu, India, 2Department of Biotechnology, Srimad Andavan Arts and Science College, Tiruchirapalli 620005, Tamil Nadu, India, 3Department of Chemistry, School of Chemical & Biotechnology, SASTRA University, Thirumalaisamudram, Thanjavur – 613401, Tamil Nadu, India.
Email: msundar77@yahoo.com
Received: 08 June 2014 Revised and Accepted: 20 Jul 2014
ABSTRACT
Objective: To evaluate the antimicrobial and anti-inflammatory effect of hexane, chloroform and ethanolic extract of Sargassum wightii.
Methods: Hexane, chlorofom and ethanolic extractions of these algae were done and evaluated for biological activity. Assay of antimicrobial activity was perfomed by disc diffusion method against various microorganisms. Assay of anti-inflammatory activity was performed in albino rats with paw edema, induced by Carrageenan.
Results: Chloroform and ethanol extracts exhibited antimicrobial activity against various microorganisms. All the extracts revealed anti-inflammatory activity, in which chloroform extract showed maximum activity in dose dependent manner.
Conclusions: Among the three different extracts tested, chloroform extract of S. wightii possess significant antimicrobial and anti-inflammatory activities. Further in-depth studies, could result in the development of a good antimicrobial and anti-inflammatory agent from this chloroform extract of S.wightii.
Keywords: Antimicrobial, Anti-inflammatory, Sargassum wightii.
INTRODUCTION
Algae are a group of organisms with little tissue differentiation, no true vascular tissues, no roots, stems or leaves and no flowers. Based on the pigments present and morphological and anatomical features, they are classified as Blue green algae (Cyanophyceae/ Myxophyceae), Green algae (Chlorophyceae), Brown algae (Phaeophyceae), and Red algae (Rhodophyceae).
The brown algae belong to a large group, the heterolontophyta, a eukaryotic group of organism distinguished most prominently by having chloroplasts surrounded by four membranes. There are about 2000 multicellular marine algae species which include many seaweed of colder northern hemisphere waters. They play an important role in the marine environment as both food and for the habitats they form [1]. Sargassum wightii is marine algae that grows 20-30 cm in length with a well marked holdfast, upper portion richly branched. They are dark-brown in color. They grow in intertidal and subtidal habitats [2]. Since they contain 8-10% mannitol, can be used as a substitute for sugar, fertilizer and medicine [3]. The remarkable medicinal properties include antibacterial, antifungal, antiprotozoal, antifertility, antiviral, anticancer, and a scope of pharmacological, hypoglycemic and antimalarial activities [4] [5] [6].
MATERIALS AND METHODS
Collection of seaweed material
The fresh seaweed of the Sargassum wightii was collected around the Mandapam region, Rameswaram, Tamilnadu, India. The seaweed was taxonomically identified and authenticated by Dr V.T. Sridharan, Professor (Rtd.), Department of Botany, National College, Trichy. The whole seaweed material was shade dried and coarsely powdered.
Preparation of extracts
Nearly 1000g of shade dried coarse material was subsequently extracted with sufficient volume of various organic solvents in the order of increasing polarity and various extracts (Hexane, Chloroform and ethanol) were prepared. Then the extract was filtered and evaporated using a vacuum rotary evaporator at 400C.
Antimicrobial Activity
Microorganisms
Pure bacterial cultures were purchased from the microbial type culture collection (MTCC), Chandigarh. The various extracts of S.wightii were tested against various microorganisms such as E. coli (MTCC 118), Bacillus cereus (MTCC 2389), Bacillus subtilis (MTCC 1305), Klebsiella pneumoniae (MTCC 1305), Staphylococcus aureus (MTCC 737), Streptococcus pyogenes (MTCC 1924), Salmonella typhimurium (MTCC 1253) and Proteus vulgaris (MTCC 1771).
Method
Assay of antimicrobial activity was performed by disc diffusion method. The Muller-Hinton agar plates were prepared and the organism was swabbed over it using a sterile cotton swab. The antimicrobial discs were placed on the surface of the agar plates and then, the plates were incubated at 37°C for 24 hrs. After incubation, the zone of inhibition was measured [7].
Anti-inflammatory activity
Animals used
Albino rats of either sex weighing 250-300g were used. The animals were maintained under suitable conditions (Temperature 25±2oc) with dark and light cycle and fed with standard dry pellets and water ad libitum throughout the experiment. The experiment was carried out after getting the necessary approval from the institutional animal ethical committee (Reg.No:790/03/ac/CPCSEA).
Carrageenin Induced Paw Edema
All rats were induced for inflammation by using 0.1ml of 1% carrageenin (w/v) solution in normal saline injected into the right hind paw of the albino rats for creating inflammation or edema [8]. Rats weighing between 250-300g were selected and divided into eleven groups of six each.
Group 1: Control group
Group 2: Sargassum wightii 100 mg/kg, p.o (Hexane extract)
Group 3: Sargassum wightii 200 mg/kg, p.o (Hexane extract)
Group 4: Sargassum wightii 300 mg/kg, p.o (Hexane extract)
Group 5: Sargassum wightii 100 mg/kg, p.o (Chloroform extract)
Group 6: Sargassum wightii 200 mg/kg, p.o (Chloroform extract)
Group 7: Sargassum wightii 300 mg/kg, p.o (Chloroform extract)
Group 8: Sargassum wightii 100 mg/kg, p.o (Ethanol extract)
Group 9: Sargassum wightii 200 mg/kg, p.o (Ethanol extract)
Group 10: Sargassum wightii 300 mg/kg, p.o (Ethanol extract)
Group 11: Standard - Indomethacin 10 mg/kg, p.o Extracts and standard drug, Indomethacin [9] were administrated orally in the albino rats. 0th hour and 3rd hour treatment i.e., right hind paw was measured (mm) and the values were statistically analyzed. The values were used to identify the percentage inhibition in paw volume by using the formula, = Control (% increase in paw volume in third hour) – Test (% increase in paw volume in third hour) X 100 / Control (% increase in paw volume in third hour)
RESULTS
Antimicrobial activity
The various extracts of S. wightii were tested against various microorganisms such as E. coli, Bacillus cereus, Bacillus subtilis, Klebsiella pneumoniae, Staphylococcus aureus, Streptococcus pyogenes, Salmonella typhimurium and Proteus vulgaris using different concentrations viz., 0.8mg, 1.2mg, 1.6mg, 2mg / disc and the results were tabulated.
Hexane extract
The Hexane extract of the Sargassum wightii exhibited no zone of inhibition and hence hexane extract possess no significant antimicrobial activity against tested microorganisms.
Chloroform extract
The chloroform extract of the Sargassum wightii tested against various microorganism and the results were presented in table 1. It showed no zone of inhibition against two microorganisms viz., Streptococcus pyogenes and Bacillus subtilis and exhibited maximum antimicrobial activity against Klebsiella pneumoniae (Fig 1).
Ethanol extract
Ethanol extract of S. wightii was tested against various microorganisms and found that it showed no activity against four microorganisms viz, E. coli, Bacillus cereus, Staphylococcus aureus, Proteus vulgaris and maximum antimicrobial activity against Salmonella typhimurium (Table 2 and Fig 2).
Table 1: Antimicrobial activity of chloroform extract of the Sargassum wightii
| S. No. | Microorganism | Chloroform extract of S.wightii | |||||
| 0.8 mg | 1.2 mg | 1.6 mg | 2 mg | Negative control | Positive control | ||
| 1. | Bacillus cereus | 6 mm | 7 mm | 10 mm | 11mm | 39 mm | |
| 2. | Klebsiella pneumonia | 6mm | 6 mm | 6 mm | 13 mm | 10 mm | |
| 3. | Proteus vulgaris | 10 mm | 11 mm | 11 mm | 12 mm | 8 mm | |
| 4. | Salmonella typhimurium | 9 mm | 12mm | 13mm | - | 8 mm | |
| 5. | E. coli | 6 mm | 6 mm | 9 mm | 11 mm | 7 mm | |
| 6. | StaphylococcusAureus | 9 mm | 9 mm | 10 mm | 10 mm | 8 mm |
Fig. 1: Antimicrobial activity of chloroform extract of the Sargassum wightii

Fig. 2: Antimicrobial activity of Ethanol extract of the Sargassum wightii
In-vivo studies
Anti-inflammatory studies
Carrageenan induced hind paw edema: Treatment with three different extracts viz hexane, chloroform and ethanol extract of S.wightii (100, 200, and 300 mg/kg.) showed a significant inhibition of paw volume. It was observed that the extracts exhibited dose dependant anti-inflammatory activity and maximum was observed at a dose of 300 mg/kg of the chloroform extract against Carrageenan induced hind paw edema ( Table 3, 4 and 5).
Table 2: Antimicrobial activity of Ethanol extract of the Sargassum wightii
| S. No. | Microorganism | Ethanol | |||||
| 0.8 mg | 1.2 mg | 1.6 mg | 2 mg | Positive control | Negative control | ||
| 1. | Salmonella typhimurium | 6 mm | 6 mm | 7mm | 12 mm | 7 mm | |
| 2. | Klebsiella pneumoniaee | 6 mm | 6 mm | 8mm | 10mm | 8 mm | |
| 3. | Bacillus subtillis | 6 mm | 6 mm | 6 mm | 11mm | 10 mm | |
| 4. | Streptococcus pyogenes | 6 mm | 6 mm | 8mm | 9mm | 10 mm |
The antimicrobial properties in Sargassum wightii may be due to multiple inhibitory properties found in algae. The results were encouraging for further in depth studies, could result in a good antibacterial agent from this marine algal source.
Table 3: Anti-inflammatory activity of Hexane extract of Sargassum wightii against Carrageenan induced paw Edema in Albino rats
| Treatment | % increase in paw volume Mean ± S.E (n = 6) | % inhibition in paw volume | |
| In 0 min | In 3 hrs | ||
| Control (0.5 ml/kg) | 37.25 ± 3.21 | 126.42 ± 9.52 | - |
| 100 mg of Hexane extract | 32.25 ± 2.8 | 70.70 ± 6.3 | 44.07 |
| 200 mg of Hexane extract | 30.64 ± 2.7 | 63.5±4.2 | 49.77 |
| 300 mg of Hexane extract | 33.64 ± 2.7 | 51.54 ± 5.1 | 59.23 |
| Indomethacin(10 mg/kg) | 31.64 ± 2.7 | 34.32 ± 3.1 | 72.85 |
Table 4: Anti-inflammatory activity of Chloroform extract of Sargassum wightii against Carrageenan induced paw Edema in Albino rats
| Treatment | % increase in paw volume Mean ± S.E (n = 6) | % inhibition in paw volume | |
| In 0 min | In 3 hrs | ||
| Control (0.5 ml/kg) | 37.25 ± 3.21 | 126.42 ± 9.52 | - |
| 100 mg of Chloroform extract | 33.25 ± 2.8 | 56.32 ± 6.3 | 55.45 |
| 200 mg of Chloroform extract | 31.25 ± 1.12 | 48.32±1.3 | 61.77 |
| 300 mg of Chloroform extract | 28.25 ± 1.12 | 40.5 ± 2.2 | 67.95 |
| Indomethacin(10 mg/kg) | 31.64 ± 2.7 | 34.32 ± 3.1 | 72.85 |
Table 5: Anti-inflammatory activity of Ethanol extract of Sargassum wightii against Carrageenan induced paw Edema in Albino rats
| Treatment | % increase in paw volume Mean ± S.E (n = 6) | % inhibition in paw volume | |
| In 0 min | In 3 hrs | ||
| Control (0.5 ml/kg) | 37.25 ± 3.21 | 126.42 ± 9.52 | - |
| 100 mg of Ethanol extract | 32.64 ± 2.7 | 79.72 ± 5.1 | 36.94 |
| 200 mg of Ethanol extract | 33.52 ± 2.7 | 65.3 ±4.6 | 48.34 |
| 300 mg of Ethanol extract | 34.23 ± 1.12 | 54.25 ± 2.2 | 57.08 |
| Indomethacin(10 mg/kg) | 31.64 ± 2.7 | 34.32 ± 3.1 | 72.85 |
DISCUSSION
Antimicrobial activity of various extracts of S.wightii revealed that the hexane extract has no significant antimicrobial activity against the tested microorganism. Chloroform and ethanol extracts exhibited significant antimicrobial activity, whereas the chloroform extract showed activity against six tested microorganism viz., Klebsiella pneumoniaee, Bacillus cereus, Staphylococcus aureus, Salmonella typhimurium, Proteus vulgaris, and E.coli.
Carrageenan induced hind paw edema study is a model used to analyze the acute inflammation mechanism. Carrageenan induced inflammatory response involves three phases of chemical mediators released in succession.[10] In the first phase (1 h) histamine and serotonin are released and is characterized by an increase in vascular permeability.
The second phase (2 h) is mediated by the release of bradykinin, an important chemical mediator of both pain and inflammation. Release of prostaglandins and cyclooxygenases products takes place in the third and final phase (3 h). It was observed that there was inhibition of edema formation after 3 hours, which indicated the acute anti-inflammatory activity. The chloroform extract of S. wightii showed an inhibition of 67.95% at a dose of 300 mg/kg, which was significant as the standard drug, which exhibited an inhibition of 72.85%. The drug showed inhibition at 3 hours which means the drug exerts its anti-inflammatory activity by preventing prostaglandin biosynthesis through inhibition of the COX enzyme.
CONCLUSION
Among the three different extracts tested for antimicrobial and anti-inflammatory activities, chloroform extract of S. wightii possess significant antimicrobial and anti-inflammatory activities. Further in-depth studies, could result in the development of a good antimicrobial and anti-inflammatory agent from this chloroform extract of marine source.
CONFLICT OF INTERESTS
Declared None
REFERENCES